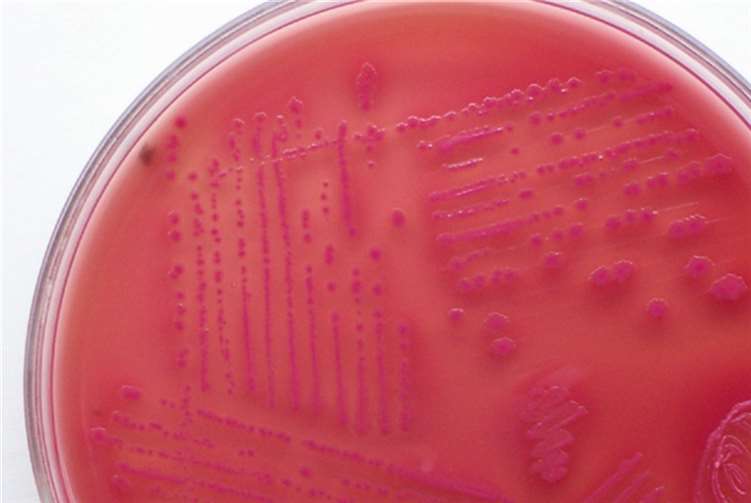
Trinkwasser: Gesamte Grafschaft betroffen!

E-Coli-Bakterien breiten sich weiter aus
Trinkwasser: Gesamte Grafschaft betroffen!
Kreisstadt/Grafschaft. Die Vorsichtsmaßnahmen wegen der Trinkwasserverunreinigung werden auf die gesamte Gemeinde Grafschaft ausgeweitet, das bestätigt die Kreisverwaltung Ahrweiler in einer aktuellen Pressemitteilung. Der Grund dafür sind neue Laborergebnisse, die die Kreisverwaltung am heutigen Freitag, 5. September, erhalten hat. Damit sind mittlerweile sämtliche Orte der Gemeinde Grafschaft betroffen, nicht nur wie bisher Birresdorf, Leimersdorf, Nierendorf und Niederich. In der Kreisstadt seien nach wie vor die östlichen Stadtteile Bad Neuenahr, Heppingen, Heimersheim, Gimmigen, Kirchdaun, Lohrsdorf, Köhlerhof, Ehlingen und Green betroffen, heißt es weiter.
Trinkwasser wird bis auf Weiteres gechlort
Das bedeutet: In der gesamten Grafschaft und in der östlichen Kreisstadt darf das Trinkwasser in den nächsten Tagen nur in abgekochtem Zustand zum Trinken, für die Mundhygiene und zur Nahrungszubereitung verwendet werden. Sobald diese Vorsichtsmaßnahme beendet werden kann, informiert die Kreisverwaltung die Bevölkerung umgehend. Dies werde jedoch frühestens am Dienstag der Fall sein, erklärte mittlerweile der Grafschafter Bürgermeister Achim Juchem gegenüber „BLICK aktuell“. Allerdings nur dann, wenn es keine neuen verunreinigten Proben gebe, die nun kontinuierlich an 28 verschiedenen Kontrollstellen gezogen werden.
Das Abkochgebot könne aufgrund der Trinkwasserverordnung erst dann aufgehoben werden, wenn mindestens drei Tage hintereinander keine Verunreinigung des Trinkwassers mehr festgestellt werde. Die Messstellen, an denen zuerst die Verunreinigungen festgestellt worden seien, seien erfreulicherweise mittlerweile wieder „sauber“, allerdings erst einen Tag. Deshalb müsse man die kommenden beiden Messergebnisse noch abwarten. „Wahrscheinlich wird es keine neuen Verunreinigungen geben – aber dafür kann man derzeit noch keine Hand ins Feuer legen“, so der Bürgermeister. Deshalb könne man jetzt nicht mehr tun, als abwarten. Sollte es allerdings doch neue Verunreinigungen geben, müsse man über weitere Maßnahmen nachdenken.
Trinkwasser wird bis auf Weiteres gechlort
Das Trinkwasser werde daher auch bis auf Weiteres gechlort, um mögliche Bakterien abzutöten. Das Chloren mache sich in Geruch und Geschmack bemerkbar, sei aber gesundheitlich unbedenklich und entspreche den Vorgaben der Trinkwasserverordnung, so die Kreisverwaltung weiter.
Das Kreis-Gesundheitsamt, die Stadt Bad Neuenahr-Ahrweiler, die Gemeinde Grafschaft sowie die Versorgungsunternehmen - Energieversorgung Mittelrhein (EVM) und Eurawasser - arbeiten mit dem Trinkwasser-Experten Prof. Dr. Martin Exner vom Hygiene-Institut der Universität Bonn zusammen. Dieser ist als einer der führenden „Hygienepäpste“ Deutschlands unter anderem Mitglied der Trinkwasserkommission der Bundesregierung. Sie alle hatten bereits mehrfach in der „Störfallkommission“ getagt, die laut Trinkwasserverordnung bei Störfällen in der Wasserversorgung einzurichten ist, und über die weiteren zu treffenden Maßnahmen beraten. Die akute Trinkwasserverunreinigung werde mit den genannten Schutzmaßnahmen wie der Chlorung durch die Trinkwasserwerke und dem Abkochen durch die Verbraucher, effektiv angegangen, verspricht das Gesundheitsamt.
Ursache ist nach wie vor nicht gefunden
Die Ursache für die gefundenen E-coli-Bakterien sei allerdings nach wie vor noch nicht geklärt. Am Freitagnachmittag waren mehrere Hochbehälter im Bereich der Gemeinde Grafschaft und der Stadt Bad Neuenahr-Ahrweiler von der Verunreinigung betroffen, untere anderem die Hochbehälter Tritschkopf, Birresdorf, Eckendorf und Lantershofen. Den Hochbehälter Birresdorf, der erst vor wenigen Monaten in Betrieb genommen wurde, habe man mittlerweile vom Netz genommen, die davon versorgten Ortschaften Birresdorf, Nierendorf, Leimersdorf und Niederich würden über den Hochbehälter Fritzdorfer Windmühle versorgt.
Die Ortschaften in der Oberen Grafschaft habe man nur deshalb dem Abkochgebot belegt, weil man nicht mit Sicherheit ausschließen könne, dass auch dort in den nächsten Tagen Verunreinigungen gemessen werden könnten. „Es handelt sich um eine reine Vorsorgemaßnahme“, unterstreicht Bürgermeister Juchem. Da gehe die Sicherheit der Bevölkerung einfach vor. Diese würden allerdings ohnehin über eigene Hochbehälter versorgt, die jedoch allesamt über den Hochbehälter Fritzdorfer Windmühle gespeist würden.
Vermutlich ein einmaliges Ereignis
Das Rätselraten über die Ursache geht weiter, derzeit geht man von einem einmaligen Ereignis aus, das wie eine Welle durch sämtliche Hochbehälter geschwappt sei und nun wieder verschwinde, so Juchem. An allen 28 Entnahmestellen - Hochbehälter, Leitungsnetze und bei Endverbrauchern - würden täglich Proben entnommen, die anschließend analysiert würden, ergänzt die Kreisverwaltung. Bislang ohne konkretes Ergebnis.
Zeitweise hatte man die zwölf Kilometer lange Transportleitung zwischen Wachtberg und Bad Neuenahr in Verdacht, doch ein möglicher Defekt sei bei dieser großen Länge nur schwer zu finden. Am Donnerstag und Freitag hätten Fachleute die Streckentraße bereits komplett abgefahren und abgegangen, ohne etwas Brauchbares zu entdecken. Es handele sich dabei um ein stabiles Stahlrohr von 40 Zentimetern Durchmesser, in dem das Wasser stellenweise mit zwölf bar Druck transportiert werde. Deshalb sei ein Defekt dort eigentlich auch schwer vorstellbar, so Bürgermeister Achim Juchem. „Wenn es dort einen Riss gäbe, würde eine meterhohe Wasserfontäne zu sehen sein.“
Kein Verbot der Gülledüngung in der Grafschaft
Eine andere Möglichkeit sei es, dass durch den ungewöhnlich starken Regen der vergangenen Tage auf irgendeine Art und Weise Gülle oder Ähnliches von den umliegenden Feldern in einen der Hochbehälter geraten sei. Aber auch das sei eigentlich nur schwer vorstellbar. „Mit anderen Worten: Wir tappen total im Dunkeln“, musste Juchem eingestehen. Ob sich im Nachhinein die Ursache überhaupt noch ermitteln lasse, sei fraglich, vor allem dann, wenn es sich tatsächlich um ein einmaliges Ereignis gehandelt habe. Ein Verbot der Gülledüngung auf der Grafschaft sei in Erwägung gezogen, aber dann verworfen worden, weil es in der gesamten Grafschaft und überhaupt im betroffenen Einzugsgebiet überhaupt keine Wassergewinnung gebe. Das Trinkwasser werde samt und sonders entweder von der Wahnbachtalsperre oder aus rechtsrheinischen Bonner Brunnen bezogen.
Beim Abkochen des Trinkwassers sei auf jeden Fall einiges zu beachten, meint das Gesundheitsamt: Das Wasser einmalig sprudelnd aufkochen lassen, am einfachsten mit einem Wasserkocher, und dann langsam mindestens zehn Minuten lang abkühlen lassen. Für die Zubereitung von Nahrung, zum Zähneputzen und zum Reinigen offener Wunden soll ausschließlich abgekochtes Leitungswasser verwendet werden. Zum Duschen, für die Toilettenspülung und andere Zwecke sei das Leitungswasser ohne Einschränkungen nutzbar.
Betroffen sind derzeit folgende Stadtteile und Orte: die gesamte Gemeinde Grafschaft sowie Bad Neuenahr, Heppingen, Heimersheim, Gimmigen, Kirchdaun, Lohrsdorf, Köhlerhof, Ehlingen und Green. -JOST-
Artikel melden
HeimatHelden: Saffig: Peter Röttgen und Dieter Sill sind für ihre Mitmenschen im Einsatz
- Rita Butz: Sehr schön verfasster Bericht , sehr zutreffend und diese beiden " Helden " üben eine Vorbildfunktion für unsere Gemeinde aus !! L. G. verbunden mit meiner höchsten Wertschätzung!!
BLICK aktuell-Bilderrätsel: Folge 1
- Rüdiger Knieps: Kesseling im Kreis Ahrweiler
Windpark für Bad Hönningen: Flächenpachtvertrag unterzeichnet
- Michael Kroeger: Bestätigung Wahlergebnis am 13.4.2026. Mark Geimer wird Stadtbürgermeister. Unterschrift Nutzungsvertrag Windkraft am 17.4.2026 durch den 1. Beigeordneten Werner Lahme. Die Vereidigung Mark Geimer als...
Erstkommunion der Kirchorte Rheinbrohl, Hammerstein, Leutesdorf
„Gottes Liebe ist wie die Sonne“
VG Bad Hönningen. Am Sonntag, dem 19. April, empfingen 19 Kinder aus Rheinbrohl, 4 Kinder aus Leutesdorf, ein Kind aus Hammerstein und ein Kind aus Bad Hönningen in der Kirche St. Peter und Paul die Erste Heilige Kommunion.
Weiterlesen
Macht mit beim BLICK aktuell-Bilderrätsel!
BLICK aktuell-Bilderrätsel: Folge 3
Jede Woche präsentieren wir Euch einen neuen Schnappschuss aus dem BLICK aktuell-Land. Die Bilder zeigen bekannte Orte, besondere Details oder überraschende Perspektiven aus der Region – doch nicht immer ist auf den ersten Blick erkennbar, was genau zu sehen ist.
Weiterlesen
Macht mit beim BLICK aktuell-Bilderrätsel!
BLICK aktuell-Bilderrätsel: Folge 4
Jede Woche präsentieren wir Euch einen neuen Schnappschuss aus dem BLICK aktuell-Land. Die Bilder zeigen bekannte Orte, besondere Details oder überraschende Perspektiven aus der Region – doch nicht immer ist auf den ersten Blick erkennbar, was genau zu sehen ist.
Weiterlesen











Auch in der Grafschaft gab es überall Lautsprecherdurchsagen und Flugblätter. Weshalb dann hier das Gegenteil suggieriert wird verstehe ich nicht. Es passt aber zu der Rolle des Internets, hier und besonders auf Facebook werden munter Vermutungen und Unterstellungen geäußert, und als Fakten verkleidet. Eine Frau aus Heimersheim fährt zum Waschen des Hundes nach Remagen, obwohl sie selbst mit dem Wasser noch duschen könnte. Eine Adenauerin schreibt, sie würde jetzt sicherheitshalber auch abkochen - was soll der Quatsch? Schuld ist der Güllesee auf der Grafschaft, den es noch nicht gibt, der ist in Grafschafter Brunnen gelaufen, die es auch nicht gibt, und das Krankenhaus ist seit Tagen überfüllt vor Wasseropfern, nur das Personal selbst hats noch nicht bemerkt (alles Auszüge aus Facebook, z.B. Gruppe "Du bist aus Neuenahr, wenn...). Vielleicht wäre es besser, das Volk bei sowas gar nicht mehr zu informieren, dann schreibt auch keiner mehr solchen Blödsinn.
Es wurden, zumindest im Stadtgebiet Bad Neuenahr-Ahrweiler, durch die Feuerwehr Lautsprecherdurchsagen gemacht. Ebenfalls wurden Flugblätter in alle betroffenen Haushalte verteilt. Demnach sollte eigentlich jeder Bürger informiert sein. Durch Blick aktuell wird und wurde ja ebenfalls berichtet.
Es sollte außer Internet Funk und Ferseher ein wichtiges Rundschreiben in alle Haushalte erfolgen,den es gibt mit Sicherheit noch Persohnen die diese Sache nicht ernst nehmen oder leider über dem Vorfall noch nicht informiert sind